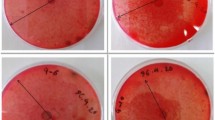

Abstract
This study proposed a novel waste utilization bioprocess for production of lactic acid and fungal biomass from waste streams by fungal species of Rhizopus arrhizus 36017 and R. oryzae 2062. The lactic acid and fungal biomass were produced in a single-stage simultaneous saccharification and fermentation process using potato, corn, wheat and pineapple waste streams as production media. R. arrhizus 36017 gave a high lactic acid yield up to 0.94–0.97 g/g of starch or sugars associated with 4–5 g/l of fungal biomass produced, while 17–19 g/l fungal biomass with a lactic acid yield of 0.65–0.76 g/g was produced by the R. oryzae 2062 in 36–48 h fermentation. Supplementation of 2 g/l of ammonium sulfate, yeast extract and peptone stimulated an increase in 8–15% lactic acid yield and 10–20% fungal biomass.
Similar content being viewed by others
Explore related subjects
Discover the latest articles, news and stories from top researchers in related subjects.Avoid common mistakes on your manuscript.
Introduction
Food processing industry produces an enormous amount of carbohydrate wastes, which pose increasing disposal costs and environmental challenges. The food processing industry generates approximately 45% of the total organic industrial pollution [1, 2]. These organic wastes are rich in biodegradable materials, making them suitable as substrates for biotechnological production of biochemicals [3–5]. Bioconversion of carbohydrate wastes is receiving increased attention in view of the fact that these wastes can act as substrates for the production of useful biomaterials and chemical intermediates. With rapid industrial development, there is a need for environmentally sustainable processes, and there is a general agreement that sustainable environmental protection can only be achieved by integrating a general environmental awareness into a company’s business functions. Recently, conversion of renewable raw materials into chemicals has become a major subject of research and process development around the world.
Global market for lactic acid and lactate (polymers excluded) production ranges at about 100,000 tons per year and shows an annual 15% growth rate [1, 6, 7]. Approximately 70% of the total lactic acid markets are used in food and food-related applications [7–9]. Lactic acid production is currently attracting a great deal of R & D interest since it is one of the most important organic acids, which has the potential of becoming a very large volume of commodity-chemical intermediate produced from renewable carbohydrates for use as feedstock for biodegradable polymers, oxygenated chemicals, plant growth regulators, environmentally friendly “green” solvents and special chemical intermediates [7, 10–12]. One of its most promising applications is its use for biodegradable and biocompatible poly-lactic acid polymers, an environmentally friendly alternative to non-biodegradable plastics derived from petrochemicals.
Lactic acid, (2-hydroxypropionic acid), is the most widely occurring multifunctional organic acid, and occurs naturally in two optical isomers, D-(−)- and L-(+)-lactic acids. Since elevated levels of the D-isomer are harmful to humans, L-lactic acid is the preferred isomer in food and pharmaceutical industries [13, 14]. Lactic acid can be produced commercially by either chemical synthesis or fermentation, and 70–80% of worldwide lactic acid is made by bacterial fermentation and the rest is produced synthetically by the hydrolysis of lactonitrile [13]. Chemical lactic acid production results only in a mixture of the two isomers, while fermentation process can yield the either form alone, or a mixture in different proportions of the two isomers, depending on the microorganism, substrate and growth conditions [4, 14]. Another significant advantage over the chemical synthesis is that biological production can use cheap raw materials, such as whey, molasses, starch, beet- and cane-sugar and other carbohydrate-rich materials [15, 16]. In commercial processes, sugars and starches have been widely used as substrates for biological lactic acid production. However, the major limitation with bacterial fermentation processes is the high cost for (1) pretreatment and hydrolysis of substrate into glucose [8, 15, 17], (2) supplementation of specific nutrients, such as yeast extract and vitamin-B [13], (3) pH control during the fermentation to maintain a high pH for bacterium growth [14, 17, 18] and (4) lactic acid recovery and purification in the downstream process [9, 14].
Fungal microorganisms have played an important role in the progress of biotechnology, being responsible for production of many primary and secondary metabolites, in particular, organic acids, antibiotics and enzymes. Research on lactic acid production by Rhizopus spp. has continued primarily because of the ease of product separation and purification and the ability of the fungus to utilize both complex carbohydrates and pentose sugars [5, 7, 19]. Among the Rhizopus fungi, R. oryzae has received the greatest interest and strain R. oryzae NRRL 395 has been recognized as one of the most suitable lactic acid producers [5, 8, 20–23]. Production of lactic acid by Rhizopus cultures is often preferred to bacterial fermentations, due to the high costs for pretreatment of raw materials and supplementation of complex nitrogen components, such as yeast extract [8, 13, 14]. Furthermore, fungal cultures, such as Rhizopus cultures, are amylolytic and they can produce lactic acid from various saccharidic materials such as potato starch without prior saccharification [5, 18, 23, 24]. Skory [7] stated that Rhizopus cells can produce more than 1.5 mol lactic acid from 1 mol of glucose under aerobic conditions and the remainder of the glucose is converted to mycelial mass, glycerol, fumarate or ethanol.
Biological conversion has an important role in waste utilization and it is likely that various food processing wastes may contain useful substrates. This investigation addressed a novel waste utilization process for production of lactic acid and fungal biomass by Rhizopus fungi. R. arrhizus 36017 and R. oryzae 2062 were involved in the investigations. Food industrial waste streams from potato, corn, wheat starch and pineapple processing were used as the production media.
Materials and methods
Microorganisms
Rhizopus oryzae 2062 was purchased from Culture Collection, Australian Food Science, Australia. R. arrhizus 36017 strain was obtained from Orange Agricultural Institute, Australia. Both strains were propagated and stored on potato dextrose agar (PDA) slants at 4°C.
Culture and fermentation medium
The composition of the pre-culture medium (g/l) was: soluble starch, 10; peptone, 5.0; yeast extract, 5.0; KH2PO4, 0.2; and MgSO4·7H2O, 0.2. This medium was autoclaved at 121°C for 20 min.
The potato, corn, wheat and pineapple wastewaters were collected from industrial processing streams in Adelaide, Australia and Guangzhou, China, mainly containing 15–30 g/l of starch or sugars. The composition of the waste streams is given in Table 1. Otherwise as stated, the waste streams were used as production media in the investigation.
Experimental set-up
Fungal spores were grown on the PDA slants at 30°C for 7 days, collected using a platinum loop, and suspended in sterilized distilled water. A 250-ml flask containing 100 ml of the pre-culture medium was inoculated with a final concentration of 105 spores/ml and incubated in a rotary shaker (150 rpm) at 30°C for 12 h. This overnight culture, as seed culture, was used to initiate growth in the production media.
The lactic acid (LA) production by the selected fungus species were conducted in 250-ml Erlenmeyer flasks containing 100-ml final volume of the production media inoculated with 5 ml of the seed culture. Agitation rate and incubation temperature were set up at 150 rpm and 30°C, respectively.
Sample preparation
During the fermentation, 100-ml samples were collected from one flask at certain interval for further analysis. Samples were filtered by 106-μm sieve for the biomass measurement. The filtered biomass was washed twice using 4 N HCl to remove the residual of calcium carbonate and the biomass concentration was determined by weighing the mass after drying at 60°C for 36 h. The filtered liquid was used to measure starch and reducing sugar. Part of the filtered liquid was centrifuged at 6,000 rpm for 10 min and the supernatant was further filtered by 0.45 μm Millipore and then diluted two or three times for lactic acid analysis by HPLC.
Analytical methods
The estimation of starch was carried out using the iodine colorimetric method described by Jin et al. [19]. Lactic acid and total sugars were measured by HPLC. A Bio-rad HPX-87H column and a refractive index detector were used with 0.004 M H2SO4 as the eluant at 65°C. Crude protein in fungal biomass was determined by the convert factor 6.25 with total Kjeldahl-N, solids and COD were measured according to procedures described in Standard Methods for the Examination of Water and Wastewater [25]. The results reported were the arithmetic mean values of the tests in triplicates. Appropriate tests of significance, analysis derivations (ANOVA) and confidence difference at 5% level were used in the data evaluations.
Conversion calculation
The volumetric concentration (C) of lactic acid and fungal biomass, yield (Y LA) of lactic acid, volumetric productivity (P LA/P FB) of lactic acid/biomass, and conversion rate (R S/R G) of starch/sugar to lactic acid were calculated by the following equations [18]:
where:
- C f :
-
final volumetric concentration in t (h) cultivation (g/l)
- C i :
-
initial volumetric concentration due to inoculation carryover, or the existing product produced during previous cultivation (g/l)
- q LA and q S :
-
quantity of lactic acid and starch or sugars (g)
- t :
-
cultivation time (h)
Conversion of starch into glucose due to the addition of water during the hydrolysis can be shown below:
The conversion factor for starch to glucose is therefore:
As n in the starch molecule becomes large, the conversion factor becomes 1.11. Therefore, complete hydrolysis of 10 g of starch yields 11.1 g of glucose and corresponds to a theoretical yield of 1.11 g lactic acid/g of starch or 1 g lactic acid/g of glucose.
Results
Kinetics of synthesis of lactic acid and fungal biomass
Characteristics of lactic acid production and fungal biomass formation by R. arrhizus 36017 and R. oryzae 2062 were investigated using potato, corn and wheat starch and pineapple waste streams containing approximately 20 g/l of starch or sugars. Kinetic profiles of lactic production and fungal biomass formation shown in Fig. 1 indicate that both R. arrhizus 36017 and R. oryzae 2062 had an enzymatic and metabolic capacity to convert the starch and sugar materials to lactic acid, demonstrating a simultaneous saccharification and fermentation (SSF) characteristic [15, 18]. These results indicated that the two Rhizopus fungi showed different characteristics in terms of saccharification and fermentation with respect to the substrate and the cultivation time. In general, the R. arrhizus 36017 had a high capability for starch hydrolysis and lactic acid production, and a high fungal biomass (FB) production was given in the R. oryzae 2062 culture.
There were four fermentation phases, lag, exponential, stationary and declining phases in terms of lactic acid and fungal cell synthesis during the course of 56 h cultivation. The lag phase was found during the first 6 h for fungal cell growth and during the first 10 h for lactic acid synthesis. During the cultivation the starch was saccharified to glucose by enzymes, such as amylase and glucoamylase, generated by the Rhizopus fungi, and the glucose was converted into the lactic acid. The fungous cell growth appeared to be rapid in 4–12 h, resulting in a sharp increase in biomass formation at a rate of 0.16–0.25 g/l·h in the R. arrhizus 36017 culture and 0.52–0.64 g/l·h in the R. oryzae 2062 culture. The R. arrhizus 36017 performed a long stationary biomass growth phase from 16 to 40 h followed by a slow biomass deduction phase. In contrast, there was a relatively short biomass stationary phase between 12 and 36 h in the R. oryzae 2062 culture followed by an obvious biomass deduction phase. Unlikely biomass formation, lactic acid production started a long lag phase. A rapid production phase was observed within 12–28 h in the R. arrhizus 36017 culture and between 12 and 36 h in the R. oryzae 2062 culture at a production rate ranging 0.49–0.54 g/l·h and 0.34–0.41 g/l·h, respectively (Table 2). These results indicated that lactic acid synthesis took place followed by the exponential cell growth phase (Fig. 1). The highest lactic acid yields ranged 0.90–0.96 g/g of starch in the R. arrhizus 36017 were obtained in 40 h, while R. oryzae 2062 gave the highest yield of 0.72–0.78 g/g starch in 48 h. A small increase in lactic acid production, but an obvious fungal biomass deduction were found after a further fermentation time over 40 h under the production conditions. As anticipated, the highest rate for lactic acid production and biomass formation was obtained with the pineapple medium, while the production and starch conversion rates were obtained in the starch media in the order as follows: corn > wheat > potato.
Effect of carbon sources
To identify the saccharification and fermentation capacity of R. arrhizus 36017 and R. oryzae 2062 using different carbon materials, both cultures were cultivated in the potato, corn, wheat and pineapple media at a concentration of approximately 20 g/l starch or sugars. Two Rhizopus fungi performed a high rate for synthesis of lactic acid and fungal cells grew very fast, in particular, in the sugar-rich pineapple medium (Fig. 1), resulting in rapid mycelial cell growth and high lactic acid synthesis rate during 24 h cultivation. This is because the fungal microorganisms easily access the glucose existing in the pineapple medium. It appeared that both strains demonstrated the highest bioaccessibility to saccharify the starch in the corn medium, while the lowest fermentation rate was given in the potato medium (Fig. 1). Table 2 shows that the R. arrhizus 36017 had a high capability for lactic acid production with a concentration ranging from 17.7 to 19.6 g/l, while a high FB production with 4.8–5.3 g/l was obtained by the R. oryzae 2062. It is interesting to note that the types of carbon sources had a little impact on the lactic acid production by the R. oryzae 2062 and on the fungal biomass synthesis by the R. arrhizus 36017. Table 2 further indicates that a postponed cultivation time from 36 to 42 h resulted in an increase in the lactic acid yield. However, this impact was very limited, if the productivity of lactic acid was taken into consideration. Both strains demonstrated a high conversion rate related to lactic acid production using corn starch and sugar materials associated with starch conversion rate (R S) of approximately 85% and sugar conversion rate (R G) of approximately 92%.
Effect of starch and sugar concentration
To determine the effect of the of carbon source concentration on the production of lactic acid and fungal biomass, initial concentration of starch or total sugar measured as glucose was adjusted from 20 to 60 g/l. Figure 2 presents the variation in volumetric concentration of lactic acid (C LA) and fungal biomass (C FB) in 48 h fermentation, and Fig. 3 shows the results of lactic acid yield (Y LA) as the starch or sugar concentration increased. The starch saccharification capacity of the two fungal species was limited as the starch concentration increased from 20 to 60 g/l under the cultivation conditions. The C LA and C FB increased as the starch concentration increased from 20 to 40 g/l in the three starch media and with increasing sugar concentration in the range of 20–60 g/l. After 48 h cultivation using the R. arrhizus 36017 and R. oryzae 2062, the C LA increased from 19.2 to 33.2 g/l and from 14.6 to 21.6 g/l, respectively, meanwhile the C FB increased from 2.0 to 4.8 g/l and from 4.5 to 11.6 g/l, respectively, as starch concentration increased from 20 to 40 g/l (Fig. 3). The Y LA decreased significantly with further increasing starch concentration from 40 to 60 g/l. This might be due to the increase in viscosity of the fermentation broth with increasing initial starch concentration, leading to low oxygen transfer efficiency for the fungal cell growth. From the lactic acid yield point of view, however, the maximum yield for R. arrhizus 36017 and R. oryzae 2062 was 0.97 and 0.77 g/g, respectively, at a lower starch concentration of approximately 20 g/l. A higher biomass yield was obtained in the R. oryzae 2062 than the R. arrhizus 36017. By comparison of the results in Fig. 2, both strains had higher fermentation efficiency when using sugar materials than the starches, and a slightly higher conversion rate for lactic acid and fungal biomass production was obtained in the corn starch medium followed by the wheat starch medium (Fig. 2).
Effect of nitrogen source
The effect of nitrogen sources on the lactic acid and fungal biomass production was investigated using corn starch and pineapple streams as production media. The media were set at starch or sugar concentration of approximately 40 g/l and were supplemented by addition of 1, 2 and 5 g/l of ammonium sulfate, urea, yeast extract and peptone. The results summarized in Table 3 revealed that R. arrhizus 36017 and R. oryzae 2062 utilized these organic and inorganic nitrogen sources for stimulating fungal cell growth and lactic production. Urea appeared to be a less favored nitrogen source for R. arrhizus 36017. In general, an increase in amount of these nitrogen sources resulted in 8–14% increase in lactic acid concentration and carbon source conversion rate. In particular, a significant improvement of the fungal cell synthesis was obtained by the supplementation of these nitrogen sources, resulting in approximately 10–20% increase in the biomass concentration (Table 3). Compared with ammonium sulfate and urea, yeast extract and peptone obviously stimulated the cell growth, resulting in high fungal biomass produced. On the other hand, it was interesting to note that an increase in ammonium sulfate from 1 to 5 g/l led to an obvious increase in lactic acid concentration, indicating that the ammonium sulfate was a favorable nitrogen source. However, with increasing these nitrogen sources in a range of 2–5 g/l the lactic acid concentration was not significantly different. A high lactic acid yield of 0.94–0.97 g/g of starch or sugar can be achieved in both media using R. arrhizus 30617 at nitrogen source level of 2 g/l ammonium sulfate, yeast extract and peptone, while producing 17–19 g/l of fungal biomass by the R. oryzae 2062. It may be that the addition of these nitrogen sources resulted in a significant improvement for lactic acid production in R. oryzae 2062 fermentation and fungal biomass formation by the R. arrhizus 36017. However, the addition of nitrogen source might be unnecessary if starch waste effluent was used for the lactic acid production by the R. arrhizus 30617.
Discussion
The potential poly-lactic acid market is expected to reach about 160,000 tons in 2003 and 390,000 tons in 2008 [1, 6]. If the poly-lactic acid is partly substituted for conventional biodegradable plastics in the near future, the quality of its raw material lactic acid required is estimated to be more than 2 billion tons per year [21]. A major barrier for the biological lactic acid production is the high cost of raw materials, which represent 40–50% of the production price [2, 9, 26]. If it is possible, however, to produce lactic acid by using waste materials instead of sugar and starch, the cost of lactic acid production would be reduced dramatically. Furthermore, there is now a worldwide emphasis on waste recovery and reuse instead of treatment and disposal, with legislation now demanding consideration of waste pollutants as a resource for manufacture of value-added products. Following our previous work on lactic acid production integrated with starch wastewater treatment by Rhizopus sp. [17, 18, 24], in the present study, it was found that strain R. arrhizus 36017 is efficient at producing lactic acid at 20–40 g/l from potato, corn, wheat and pineapple waste streams, corresponding to a starch and sugar conversion rate of 84–95% and 93–97%, respectively, while the strain R. oryzae 2062 demonstrated a high fungal biomass production with 15–20 g/l associated with producing approximately 20 g/l of lactic acid using these waste streams as production media. The biochemical kinetics of the SSF of lactic acid production using R. arrhizus 36017 and R. oryzae 2062 studied indicated that R. arrhizus 36017 and R. oryzae 2062 had an ability to perform a single SSF stage process for lactic acid production using starch and sugar materials. Two fungous microorganisms had a high enzymatic and metabolic capability to not only carry out an SSF process and but also to utilize starch or sugar waste material as a sole source for lactic acid production. Under the same cultivation conditions, R. arrhizus 36017 demonstrated a higher overall saccharification and fermentation rate for lactic acid production, while a higher fungal biomass production was obtained by the R. oryzae 2062. The fungal biomass contained approximately 40–45% (w/w) crude protein. Therefore, the proposed fermentation process for lactic acid and fungal biomass production may be possible from starch- or sugar-based waste materials by the two Rhizopus strains.
Rhizopus fungi have been known for their capacity to secrete amylase to produce lactic acid from starchy substrates such as potato starch without prior saccharification [17, 23]. The physiology of R. oryzae has been studied usually in connection to the lactic acid production. The species of fungus Rhizopus, such as R. oryzae and R. arrhizus have been used not only for fermentation of local foods in China and Southeast Asia, but also in food and chemical industries [19, 20]. R. oryzae NRRL 395 was extensively researched and has been recognized as one of the most suitable lactic acid producers [4, 8, 22]. The lactic acid production from 60 to 80 g/l using the R. oryzae NRRL 395 was obtained in more than 3 days batch process with a lactic acid yield between 65 and 78% [12, 16, 27]. The ability of Rhizopus to aerobically produce lactic acid with addition of nutrients has been studied [5, 22, 28]. Strain R. oryzae ATCC 52311 produced 83 g/l lactic acid with a yield of 0.88 g lactic acid/g of glucose consumed in culture containing glucose and ammonium sulfate and other inorganic salts [28]. R. oryzae and R. arrhizus simultaneously saccharified and fermented corn and potato pulp to lactic acid [3, 5, 12, 23]. Khalaf [3] reported that two prototrophic hybrids mutated from R. oryzae Leu, and R. arrhizus Cys2 produced lactic acid with a concentration of 75 g/l. The range of medium composition for lactic acid production by R. oryzae has been reported using glucose or starch as carbon sources with supplementation of (g/l) (NH4)2SO4 1–6, MgSO4.7H2O 0.05–0.25, KH2PO4 0.12–0.6 and ZnSO4 7H2O 0.02–0.09 [11, 21, 27]. Woiciechowski et al. [29] applied enough ammonium sulfate to obtain a C/N ratio of 5, whereas they reported that the highest lactic acid yield was obtained when a C/N ratio of 3.5 was used in a lactic acid fermentation using R. oryzae. The results from Taherzadeh et al. [11] indicated that a poor medium implying nitrogen starvation can lead to a decrease in biomass yield and production of more lactic acid by R. oryzae. However, our current results along with previous studies [8, 10, 12, 17, 21, 24] suggested that an increase in the nitrogen amount at a low-level range, such as lower than 5 g/l, resulted in an increase in lactic acid, in particular, FB production, in a process involved by the Rhizopus strains. Hofvendahl and Hahn-Hagerdal [13] reported that the addition of nutrients, such as nitrogen and phosphorus, and higher nutrient concentrations generally had a positive effect on the lactic acid production in the bacterial fermentation processes.
In conclusion, although the current results along with our previous investigations showed significantly reliable lactic acid and fungal biomass production using the R. oryzae 2062 and R. arrhizus 36017 from a variety of starch- or sugar-based materials, further studies using laboratory- and pilot-scale bioreactors and cost/benefit analysis are required to evaluate fully such a new integrated fermentation process. Some critical issues, such as low bioaccessibility and mass transfer efficiency caused by the viscous mycelial broth, need to be investigated. Associated with these, an inhibition by the lactic acid itself may be an important factor which affected the microbial accessibility and fungal cell growth, as well as the lactic acid synthesis [10]. Therefore, these phenomena need to be addressed in a further SSF investigation.
References
Akerberg C, Zacchi G (2000) An economic evaluation of the fermentative production of lactic acid from wheat flour. Bioresour Technol 75:119–126
Akerberg C, Hofvendahl K, Zacchi G, Hahn-Hagerdal B (1998) Modelling the influence of pH, temperature, glucose and lactic acid concentrations on the kinetics of lactic acid production by Lactococcus lactis ssp. lactis ATCC 19435 in whole-wheat flour. Appl Microbiol Biotechnol 49:682–690
Anuradha R, Suresh AK, Venkatesh KV (1999) Simultaneous saccharification and fermentation of starch to lactic acid. Process Biochem 35:367–375
APHA (1992) Standard methods for examination of water and wastewater, 16th edn. American Public Health Association, Washington
Bogaert J, Coszach P (2000) Poly(lactic acids): a potential solution to plastic waste dilemma. Macromol Symp 153:287–303
Bulliuger HJ, Steinaecker J, Weller A (1999) Concepts and methods for a production integrated environmental protection. Int J Prod Econ 60–61:35–42
Datta R, Tsai SP, Bonsignor P, Moon S, Frank J (1995) Technological and economic potential of poly(lactic acid) and lactic acid derivatives. FEMS Microbiol Rev 16:221–231
Hakki EE, Akkaya MS (2001) RT-PCR amplification of a Rhizopus oryzae lactate dehydrogenase gene fragment. Enzyme Microbiol Technol 28:259–264
Hang YD, Hamamci H, Woodams E (1989) Production of L(+)-lactic acid by Rhizopus oryzae immobilized in calcium alginate gels. Biotechnol Lett 11:119–120
Hofvendahl K, Hahn-Hagerdal B (2000) Factors affecting the fermentative lactic acid production from renewable resources. Enzyme Microb Technol 26:87–107
Huang LP, Jin B, Lant P, Zhou JT (2003) Biotechnological production of lactic acid integrated with potato wastewater treatment by Rhisopus arrhizus. J Chem Technol Biotechnol 78:889–906
Huang LP, Jin B, Lant P (2005) Simultaneous saccharification and fermentation for lactic acid production from potato starch wastewater treatment by Rhizopus arrhizus and Rhizopus oryzae. Biochem Eng J 23(3):265–276
Jin B, van Leeuwen J, Yu Q, Patel B (1999) Screening and selection of microfungi for microbial biomass protein production and water reclamation from starch processing wastewater. J Chem Technol Biotechnol 74:106–110
Jin B, Huang LP, Lant P (2003) Rhizopus arrhizus—a producer for simultaneous saccharification and fermentation of starch waste materials to L(+)-lactic acid. Biotechnol Lett 25:1983–1987
Khalaf SA (2001) Lactic acid production by interspecific hybrids of Rhizopus strains from potato processing peel waste. Egypt J Microbiol 36(1):89–102
Martak J, Schlosser S, Sabolova, Kristofikova L, Rosenberg M (2003) Fermentation of lactic acid with Rhizopus arrhizus in a stirred tank reactor with a periodical bleed and feed operation. Process Biochem, pp 1–11
Oda Y, Saito K, Yamauchi H, Mori M (2002) Lactic acid fermentation of potato pulp by the fungus Rhizopus oryzae. Current Microbiol 45:1–4
Richter K, Berthold C (1998) Biotechnological conversion of sugar and starchy crops into lactic acid. J Agri Eng Res 71:181–191
Rosenberg M, Kristofikova L (1995) Physiological restriction of the L-lactic acid production by Rhizopus arrhizus. Acta Biotechnol 15:367–374
Skory CD (2000) Isolation and expression of lactate dehydrogenase genes from Rhizopus oryzae. Appl Environ Mocrobiol 66(6):2343–2348
Taherzadeh M, Fox M, Hjorth H, Edebo L (2003) Production of mycelium biomass and ethanol from paper pulp sulfite liquor by Rhizopus oryzae. Bioresource Technol 88:167–177
Tsai SP, Moon SH (1998) An integrated bioconversion process for production of L-lactic acid from starchy potato feed stocks. Appl Biochem Biotechnol 70–72:417–428
Tsao GT, Cao NJ, Du J, Gong CS (1999) Production of multifunctional organic acids from renewable resources. Adv Biochem Eng Biotechnol 65:245–277
Ueno T, Ozawa Y, Ishikawa M, Nakanishi K, Kimura T (2003) Lactic acid production using two food processing wastes, canned pineapple syrup and grape invertase, as substrate and enzyme. Biotechnol Lett 25:573–577
Woiciechowski AL, Soccol CR, Ramos LP, Pandey A (1999) Experimental design to enhance the production of L-(+)-lactic acid from stream-exploded wood hydrolysate using Rhizopus oryzae in a mixed-acid fermentation. Process Biochem 34:949–955
Yang CW, Lu ZJ, Tsao GT (1995) Lactic acid production by pellet-form Rhizopus oryzae in a submerged system. Appl Biochem Biotechnol 51–52:57–71
Yin P, Nishina N, Kosakai Y, Yahiro K, Park Y, Okabe M (1997) Enhanced production of L(+)-lactic acid from corn starch in a culture of Rhizopus oryzae using an air-lift bioreactor. J Ferment Bioeng 84:249–253
Yu RC, Hang YD (1989). Kinetics of direct fermentation of agricultural commodities to L(+)-lactic acid by Rhizopus oryzae. Biotechnol Lett 11:597–600
Zhou Y, Dominguez JM, Cao N, Du J, Tsao GT (1999) Optimization of L-Lactic acid production from glucose by Rhizopus oryzae ATCC 52311. Appl Biochem Biotechnol 77–79:401–407
Acknowledgements
This study was funded by Discovery Grand from Australian Research Council (DP0452516).
Author information
Authors and Affiliations
Corresponding author
Rights and permissions
About this article
Cite this article
Jin, B., Yin, P., Ma, Y. et al. Production of lactic acid and fungal biomass by Rhizopus fungi from food processing waste streams. J IND MICROBIOL BIOTECHNOL 32, 678–686 (2005). https://doi.org/10.1007/s10295-005-0045-4
Received:
Accepted:
Published:
Issue Date:
DOI: https://doi.org/10.1007/s10295-005-0045-4